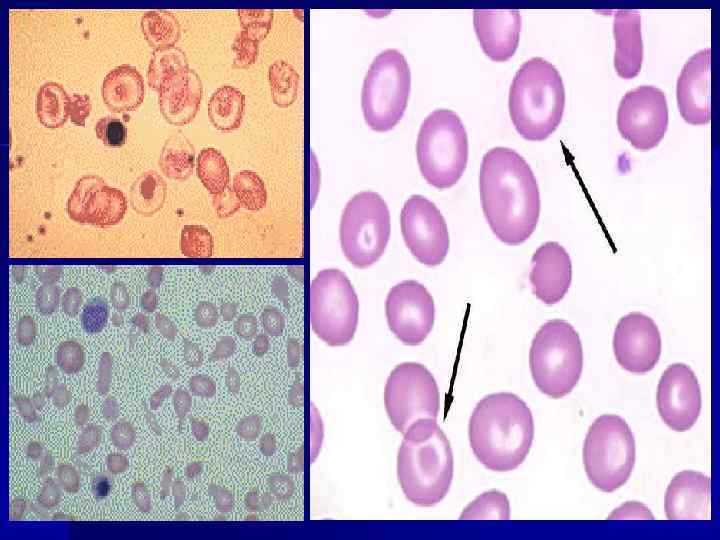

Гемолитические анемии у детей.ppt
- Количество слайдов: 32
 ГЕМОЛИТИЧЕСКИЕ АНЕМИИ У ДЕТЕЙ Профессор Т. Л. Настаушева
ГЕМОЛИТИЧЕСКИЕ АНЕМИИ У ДЕТЕЙ Профессор Т. Л. Настаушева
 Гемолитическая анемия – Заболевание, связанное с укорочением жизни эритроцитов (N 120 дней), когда процессы разрушения преобладают над процессами образования Анемия Возраст Hb г/л До 7 дней < 170 7 – 14 дней < 145 1 мес – 6 лет 6 – 12 лет > 12 лет < 120 < 115 < 120
Гемолитическая анемия – Заболевание, связанное с укорочением жизни эритроцитов (N 120 дней), когда процессы разрушения преобладают над процессами образования Анемия Возраст Hb г/л До 7 дней < 170 7 – 14 дней < 145 1 мес – 6 лет 6 – 12 лет > 12 лет < 120 < 115 < 120
 Патогенез ГА Гемолиз Внутриклеточный в печени, сел-ке макрофагами- глобин+Нв, Железотрансферрин, гем-нек. билирубин (>), в печени коньюгация-уробилиноген кала (>), уробилиноген мочи (>) Гемолиз внутрисосудистый глобин+Нв тетрамер и димер (>), метенальбумин (>), розовый цвет плазмы, Нв в комплексе с гаплоглобином, печень коньюгация, моча (уробилиноген>), Нв димер в почку-Нв мочи(>), гемосидерин в моче (>) Анемия, м. б. гипопластические и апластическте кризы
Патогенез ГА Гемолиз Внутриклеточный в печени, сел-ке макрофагами- глобин+Нв, Железотрансферрин, гем-нек. билирубин (>), в печени коньюгация-уробилиноген кала (>), уробилиноген мочи (>) Гемолиз внутрисосудистый глобин+Нв тетрамер и димер (>), метенальбумин (>), розовый цвет плазмы, Нв в комплексе с гаплоглобином, печень коньюгация, моча (уробилиноген>), Нв димер в почку-Нв мочи(>), гемосидерин в моче (>) Анемия, м. б. гипопластические и апластическте кризы
 Клинические симптомы гемолитической анемии n n n Бледность Желтуха Увеличение селезенки Камни в желчном пузыре (+Са) Анемия Ретикулоцитоз ↑ билирубин ↑ гаптоглобин Уробилиноген в моче и кале КМ гиперплазия эритроидного ростка М. б. аплазия
Клинические симптомы гемолитической анемии n n n Бледность Желтуха Увеличение селезенки Камни в желчном пузыре (+Са) Анемия Ретикулоцитоз ↑ билирубин ↑ гаптоглобин Уробилиноген в моче и кале КМ гиперплазия эритроидного ростка М. б. аплазия

 Клиника анемии –рез-т гипоксии, компенс. ССС и ДС Слабость, гол. боль, шум в ушах, утомл. , сонливость, странности пов. , аменорея, р-ва ж. к. т. , ссн. , шок. n Тяжелая ( гем. криз): озноб, лих-ка, боли в спине, животе, шок. n
Клиника анемии –рез-т гипоксии, компенс. ССС и ДС Слабость, гол. боль, шум в ушах, утомл. , сонливость, странности пов. , аменорея, р-ва ж. к. т. , ссн. , шок. n Тяжелая ( гем. криз): озноб, лих-ка, боли в спине, животе, шок. n
 Диагностика гемолитической анемии n n n Hb Эритроциты Средний V эритроцитов Среднее содержание Hb Гипохромия <30% Анизоцитоз – размер Пойкилоцитоз – форма Осмотическая стойкость эритроцитов (N мин. 0, 44 и макс. <0, 32) Шистоциты – разрушение Овалоциты – повреждение мембраны Мешеневидные - ↓ Hb
Диагностика гемолитической анемии n n n Hb Эритроциты Средний V эритроцитов Среднее содержание Hb Гипохромия <30% Анизоцитоз – размер Пойкилоцитоз – форма Осмотическая стойкость эритроцитов (N мин. 0, 44 и макс. <0, 32) Шистоциты – разрушение Овалоциты – повреждение мембраны Мешеневидные - ↓ Hb
 ПРИЗНАКИ РАЗЛИЧНЫХ ТИПОВ ГЕМОЛИЗА Локализация Внутрисосудистый Внутриклеточный (РЭС, селезенка) Патогенез Присутствие гемолизинов (эндо, экзо), энзимопатия ↓ Осм. СЭ (врожденная, приобретенная) Течение Острое, хроническое с обострениями Хроническое с обострениями Селезенка ↑ нерезкое ↑ значительное Печень болезненность б/болезненность
ПРИЗНАКИ РАЗЛИЧНЫХ ТИПОВ ГЕМОЛИЗА Локализация Внутрисосудистый Внутриклеточный (РЭС, селезенка) Патогенез Присутствие гемолизинов (эндо, экзо), энзимопатия ↓ Осм. СЭ (врожденная, приобретенная) Течение Острое, хроническое с обострениями Хроническое с обострениями Селезенка ↑ нерезкое ↑ значительное Печень болезненность б/болезненность
 ПРИЗНАКИ РАЗЛИЧНЫХ ТИПОВ ГЕМОЛИЗА (продолжение) Морфологические изменения эритроцитов - + ОСЭ N ↓ или N Гемосидероз органов - + Гемосидерин в моче + - Эффект спленэктомии - + Ig G M
ПРИЗНАКИ РАЗЛИЧНЫХ ТИПОВ ГЕМОЛИЗА (продолжение) Морфологические изменения эритроцитов - + ОСЭ N ↓ или N Гемосидероз органов - + Гемосидерин в моче + - Эффект спленэктомии - + Ig G M
 КЛАССИФИКАЦИЯ ПРИОБРЕТЕННОЙ ГЕМОЛИТИЧЕСКОЙ АНЕМИИ n n n n Иммунная Инфекционная Токсическая и лекарственная При термических повреждениях При ДВС – синдроме ГУС При трансфузионных реакциях
КЛАССИФИКАЦИЯ ПРИОБРЕТЕННОЙ ГЕМОЛИТИЧЕСКОЙ АНЕМИИ n n n n Иммунная Инфекционная Токсическая и лекарственная При термических повреждениях При ДВС – синдроме ГУС При трансфузионных реакциях
 Аутоиммунная ГА АТ к эр. (метод Кумбса), прямые (на эр. ) и непрямые (в сыв-ке) n С тепловыми АТ (прямые, Ig. G)–при СКВ, лейкозы, лек-ва (пениц. , цефалосп. ) n С холодовыми АТ (пр. , непр. Ig. M) при инфекциях-микопл. , ЭБВ, опухоли, лек -ва, СЗСТ. n
Аутоиммунная ГА АТ к эр. (метод Кумбса), прямые (на эр. ) и непрямые (в сыв-ке) n С тепловыми АТ (прямые, Ig. G)–при СКВ, лейкозы, лек-ва (пениц. , цефалосп. ) n С холодовыми АТ (пр. , непр. Ig. M) при инфекциях-микопл. , ЭБВ, опухоли, лек -ва, СЗСТ. n

 Клиника Начало внезапное, бледность, желтуха с темной мочой, печень +, -, сел-ка >, рет. >, билир. >, р. Кумбса + n Инфекционная – гем. стрептококк, менингококк или прямое разрушение – малярия, бартонелла n
Клиника Начало внезапное, бледность, желтуха с темной мочой, печень +, -, сел-ка >, рет. >, билир. >, р. Кумбса + n Инфекционная – гем. стрептококк, менингококк или прямое разрушение – малярия, бартонелла n
 Пароксизмальная ночная гем-урия (Маркиафавы. Микели) n n n Сенсибилизация к С (эр. чувствительны к лизису клеток С ). Эпизоды гемолиза с гем-урией во сне. Провокация-инфекции, прием железа, вакцины, менстр. Клиника –боль в животе, спине, Нв в моче, сел-ка> Переливания плазмы, пр-ты железа п/пок.
Пароксизмальная ночная гем-урия (Маркиафавы. Микели) n n n Сенсибилизация к С (эр. чувствительны к лизису клеток С ). Эпизоды гемолиза с гем-урией во сне. Провокация-инфекции, прием железа, вакцины, менстр. Клиника –боль в животе, спине, Нв в моче, сел-ка> Переливания плазмы, пр-ты железа п/пок.
 КЛАССИФИКАЦИЯ ВРОЖДЕННОЙ ГЕМОЛИТИЧЕСКОЙ АНЕМИИ n n n Гемоглобинопатии (серповидноклеточная анемия, серповидноклеточные синдромы: S талассемия, SC гемоглобинопатия, талассемии) Дефект мембраны (сфероцитоз, эллиптоцитоз, стоматоцитоз, пиропойкилоцитоз) Дефицит ферментов: глюкозо-6 фосфатдегидрогеназы, пируваткиназы, гексокиназы.
КЛАССИФИКАЦИЯ ВРОЖДЕННОЙ ГЕМОЛИТИЧЕСКОЙ АНЕМИИ n n n Гемоглобинопатии (серповидноклеточная анемия, серповидноклеточные синдромы: S талассемия, SC гемоглобинопатия, талассемии) Дефект мембраны (сфероцитоз, эллиптоцитоз, стоматоцитоз, пиропойкилоцитоз) Дефицит ферментов: глюкозо-6 фосфатдегидрогеназы, пируваткиназы, гексокиназы.
 гемоглобинопатии Изменение б/х особ. Нв, 500 вариаций. n Нарушение строения цепей a и β n Патология на 16 хром. – альфа таласемия n Патология на 11 хром. – бета таласемия n
гемоглобинопатии Изменение б/х особ. Нв, 500 вариаций. n Нарушение строения цепей a и β n Патология на 16 хром. – альфа таласемия n Патология на 11 хром. – бета таласемия n
 ТИПЫ Hb ПРИ ГЕМОГЛОБИНОПАТИЯХ И ТАЛАССЕМИЯХ Здоровые дети ß – талассемия АА (А 2 < 4%, F < 2%) F ↑ А 2 ↑ АS 2 ↑ Серповидно. AS клеточная анемия SS SA α – талассемия A AH
ТИПЫ Hb ПРИ ГЕМОГЛОБИНОПАТИЯХ И ТАЛАССЕМИЯХ Здоровые дети ß – талассемия АА (А 2 < 4%, F < 2%) F ↑ А 2 ↑ АS 2 ↑ Серповидно. AS клеточная анемия SS SA α – талассемия A AH
 ТАЛАССЕМИИ - это n гетерогенная группа наследственнообусловленных гипохромных анемий, в основе которых лежит нарушение структуры цепей глобина при отсутствии нарушений в химической структуре гемоглобина
ТАЛАССЕМИИ - это n гетерогенная группа наследственнообусловленных гипохромных анемий, в основе которых лежит нарушение структуры цепей глобина при отсутствии нарушений в химической структуре гемоглобина


 ОСОБЕННОСТИ ТАЛАССЕМИЙ Тип Анемия V эртов β легкаятяжелая < > > β-Q легкаяумереная < N > α гетерозиготный - N или < N N гомозиготный легкая < N или < N < Hb H Hb Bart N дополн. ген умерен % Hb A 2 %Hb F
ОСОБЕННОСТИ ТАЛАССЕМИЙ Тип Анемия V эртов β легкаятяжелая < > > β-Q легкаяумереная < N > α гетерозиготный - N или < N N гомозиготный легкая < N или < N < Hb H Hb Bart N дополн. ген умерен % Hb A 2 %Hb F
 Талассемия Симптом Большая (начало в грудном возрасте) Малая (средне тяжелая) Бессимптомная ↑ селезенки ++++ / ++++ -/+ Желтуха +++ +/+++ -/+ Изменение скелета ++++ ++/++++ - Трансфузии крови +/+++ -/+ - Анемия (Hb, г/л) < 70 70 - 100 >100 Микроцитоз + + + Ретикулоциты ++/++++ +/+++ - Изменение морфологии ++++ ++ + Hb F 10 – 95% N до 10% Hb A 2 N или ↑ (> 3, 5%)
Талассемия Симптом Большая (начало в грудном возрасте) Малая (средне тяжелая) Бессимптомная ↑ селезенки ++++ / ++++ -/+ Желтуха +++ +/+++ -/+ Изменение скелета ++++ ++/++++ - Трансфузии крови +/+++ -/+ - Анемия (Hb, г/л) < 70 70 - 100 >100 Микроцитоз + + + Ретикулоциты ++/++++ +/+++ - Изменение морфологии ++++ ++ + Hb F 10 – 95% N до 10% Hb A 2 N или ↑ (> 3, 5%)
 α‑талассемия • При полном отсутствии синтеза α‑цепи у плода не синтезируется фетальный гемоглобин, развивается водянка, в результате чего наступает смерть
α‑талассемия • При полном отсутствии синтеза α‑цепи у плода не синтезируется фетальный гемоглобин, развивается водянка, в результате чего наступает смерть
 β‑талассемия
β‑талассемия

Серповидно-кл. анемия В США 1: 2 -3 тыс. нов-х. 1 -е место среди врожд. заб. которые скринируются. n Тяжелая, иммунодефицит и инфекции n Оклюзионные поражения сосудов n
Серповидно-кл. анемия В США 1: 2 -3 тыс. нов-х. 1 -е место среди врожд. заб. которые скринируются. n Тяжелая, иммунодефицит и инфекции n Оклюзионные поражения сосудов n

 МЕХАНИЗМ КЛИНИЧЕСКИХ ПРОЯВЛЕНИЙ ПРИ СЕРПОВИДНО-КЛЕТОЧНОЙ АНЕМИ Аномальный Hb S Серповидность эритроцитов Ускоренное разрушение эр. - желтуха -камни Ж. П. Нарушение Скопление эр. кровообращения в сосудах в органах Анемия • инсульт • гематурия ↑активность КМ • кости-асептический гиперплазия КМ • остеопороз, остеосклероз • • некроз легкие пневмония, инфаркт кожа – язва сердце↑, недостаточность ЖКТ – боли, запор печень – некроз клеток, застой >селезенки, фиброз > печени, фиброз
МЕХАНИЗМ КЛИНИЧЕСКИХ ПРОЯВЛЕНИЙ ПРИ СЕРПОВИДНО-КЛЕТОЧНОЙ АНЕМИ Аномальный Hb S Серповидность эритроцитов Ускоренное разрушение эр. - желтуха -камни Ж. П. Нарушение Скопление эр. кровообращения в сосудах в органах Анемия • инсульт • гематурия ↑активность КМ • кости-асептический гиперплазия КМ • остеопороз, остеосклероз • • некроз легкие пневмония, инфаркт кожа – язва сердце↑, недостаточность ЖКТ – боли, запор печень – некроз клеток, застой >селезенки, фиброз > печени, фиброз
 ПРОВОЦИРУЮЩИЕ ГЕМОЛИТИЧЕСКИЙ КРИЗ ФАКТОРЫ ПРИ 6 ФДГ-ДЕФИЦИТЕ ЛЕКАРСТВА n ХИНОЛИНОВЫЕ ПРЕПАРАТЫ (ДЕЛАГИЛ, …) n СУЛЬФАНИЛАМИДНЫЕ (БИСЕПТОЛ, СУЛЬФАСАЛАЗИН, …) n НПС (АСПИРИН, АНАЛЬГИН, …) n А/Б (ЛЕВОМИЦЕТИН, ФУРАЗОЛИДОН, …) n ВИТАМИН К РАСТИТЕЛЬНЫЕ ПРОДУКТЫ: СТРУЧКОВЫЕ (БОБЫ - ФАВИЗМ) ВИРУСЫ (ГРИПП, …)
ПРОВОЦИРУЮЩИЕ ГЕМОЛИТИЧЕСКИЙ КРИЗ ФАКТОРЫ ПРИ 6 ФДГ-ДЕФИЦИТЕ ЛЕКАРСТВА n ХИНОЛИНОВЫЕ ПРЕПАРАТЫ (ДЕЛАГИЛ, …) n СУЛЬФАНИЛАМИДНЫЕ (БИСЕПТОЛ, СУЛЬФАСАЛАЗИН, …) n НПС (АСПИРИН, АНАЛЬГИН, …) n А/Б (ЛЕВОМИЦЕТИН, ФУРАЗОЛИДОН, …) n ВИТАМИН К РАСТИТЕЛЬНЫЕ ПРОДУКТЫ: СТРУЧКОВЫЕ (БОБЫ - ФАВИЗМ) ВИРУСЫ (ГРИПП, …)
 Лечение n Ø Ø Ø Ø Ø Врожденная гемолитическая анемия – симптоматическое: Удаление селезенки Переливание эр. массы (при Hb <50 г/л) Болевые кризы – анальгетики, наркотики При железе>, десферал Фолиевая к-та 1 мг х 2 р/с Приобретенная гемолитическая анемия: Глюкокортикоиды (2 – 10 мг/кг/сут) Плазмаферез в/в Ig 1 г/кг и выше Цитостатические препараты (ритуксимаб -мабтера) Спленэктомия -?
Лечение n Ø Ø Ø Ø Ø Врожденная гемолитическая анемия – симптоматическое: Удаление селезенки Переливание эр. массы (при Hb <50 г/л) Болевые кризы – анальгетики, наркотики При железе>, десферал Фолиевая к-та 1 мг х 2 р/с Приобретенная гемолитическая анемия: Глюкокортикоиды (2 – 10 мг/кг/сут) Плазмаферез в/в Ig 1 г/кг и выше Цитостатические препараты (ритуксимаб -мабтера) Спленэктомия -?
 ЭКСИДЖАД • • Комплексообразующий препарат, обладающий высоким сродством к железу (III) и связывающим его в соотношении 2: 1 Усиливает экскрецию железа, преимущественно с калом Показания - хроническая посттрансфузионная перегрузка железом у взрослых и детей в возрасте 2 лет и старше Доза - 20 мг/кг массы тела
ЭКСИДЖАД • • Комплексообразующий препарат, обладающий высоким сродством к железу (III) и связывающим его в соотношении 2: 1 Усиливает экскрецию железа, преимущественно с калом Показания - хроническая посттрансфузионная перегрузка железом у взрослых и детей в возрасте 2 лет и старше Доза - 20 мг/кг массы тела


